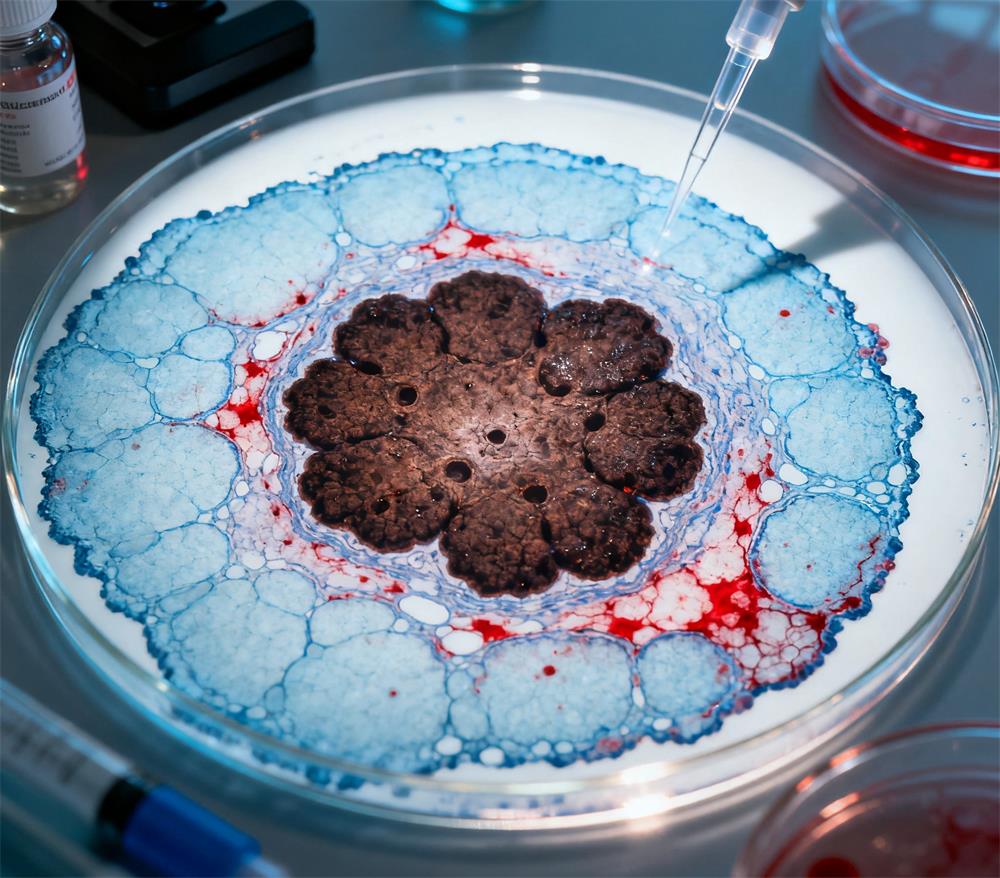

发布时间 :2025-22-09
广州市科之蓝仪器有限公司成立于2008年,总部设立在中国广州。十多年来,科之蓝凭借专业的技术与优质的服务、及时响应的售后与商务团队,赢得了众多国内外知名品牌的信任并成为合作伙伴,力在为客户提供国内外一流的科研实验室仪器,助力高校、企业、科研院所以及各大医院的学术研究。产品和技术覆盖分子细胞生物学研究室、理化工业科学研究室、动物实验研究室三大主线研究领域。
在现代医学诊断的核心领域——病理学中,技术的精确性、可靠性和效率直接关系到患者的生命健康。徕卡显微系统(Leica Microsystems)作为全球显微技术领域的领导者,其病理学解决方案贯穿了从组织制备到数字化诊断的完整工作流程,通过一系列尖端技术持续推动着病理学的创新与变革。


徕卡病理技术并非单一设备,而是一个高度整合的“工作流解决方案”,涵盖了传统病理学的每一个关键环节。
1. 组织制备:标准化与自动化的基石
精准的诊断始于完美的样本制备。徕卡在此阶段的技术优势体现在:
全自动组织脱水机(如 Leica Peloris):采用双重真空、压力交互技术和智能试剂管理,确保了组织处理的极致均匀性,彻底消除了传统脱水机因试剂交叉污染和浓度衰减导致的“批次差异”,为后续的染色和诊断提供了无与伦比的重复性和可靠性。
石蜡包埋系统:精准的温度控制和人性化设计,确保组织定向准确,形成高质量的石蜡块,为切片打下坚实基础。
病理切片机(如 Leica RM):以其卓越的刚性、精密的进样精度和极致的稳定性闻名于世。无论是常规切片还是要求的超薄切片(如2-3μm),都能提供无震動、无划痕的平整切片,极大减少了诊断过程中的技术干扰。
2. 染色与染色创新:从常规到多重荧光
染色是让组织“开口说话”的关键步骤。
自动染色机(如 Leica ST5020):实现了苏木精-伊红(H&E)染色的全自动化和标准化,通过精确的试剂分配、时间控制和温度管理,确保每一天、每一批次的染色结果都高度一致,减少了因人工操作带来的变异。
特殊染色与免疫组化(IHC):徕卡提供完整的IHC解决方案,其自动化平台(如 BOND系列)通过高效的抗原修复和灵敏的检测系统,确保了标志物表达的准确定位和定量,为癌症分型和靶向治疗提供关键依据。
多色荧光技术(如 LAS X Multi-View模块):在面对复杂的肿瘤微环境或需要同时检测多个生物标志物时,徕卡的多色荧光成像技术允许在同一张切片上进行多重标记和成像,并通过先进的光谱拆分(Spectral Unmixing)算法消除荧光串色,为研究人员提供更丰富的空间生物学信息。
3. 数字病理与人工智能:迈向未来的桥梁
这是徕卡技术战略的重中之重,旨在将传统的显微镜诊断带入数字化、智能化的新时代。
高通量扫描仪(如 Aperio系列):这些扫描仪能够快速、全自动地将整张病理玻片转化为高分辨率的数字图像(Whole Slide Image, WSI)。其高速、高吞吐量的特点满足了大型医院和参考实验室的海量扫描需求。
一体化数字病理平台(如 Aperio Veridio):将扫描仪、集成显微镜和摄像头融为一体,为病理科提供了从快速玻片预览到全片数字化的灵活选择,实现了传统光学与数字化的无缝衔接。
AI就绪平台:徕卡的数字病理解决方案专为集成人工智能(AI)算法而设计。其开放的图像格式和兼容性允许第三方AI应用直接在其图像管理软件(如 Aperio eSlide Manager)上运行,助力病理医生进行自动化病灶识别、定量分析和辅助诊断,大幅提升诊断效率和准确性。
卓越的图像质量:从光学显微镜的复消色差物镜到扫描仪的精密光学系统,徕卡始终提供最高分辨率和色彩保真度的图像,这是准确诊断的根本。
无与伦比的重复性:通过全流程的自动化与标准化,最大限度地减少了人为操作和技术差异,确保了诊断结果的可靠性和可比性。
工作流效率提升:自动化设备解放了技术员的人力,数字病理打破了时间和空间的限制,实现了远程会诊和高效协作,优化了病理科的运营管理。
面向未来的开放性:徕卡积极拥抱AI和云计算,其平台的设计哲学是开放与整合,而非封闭,这使得用户能够利用不断发展的算法工具,持续提升诊断能力。
徕卡病理技术广泛应用于:
临床诊断:肿瘤病理、血液病理、神经病理等各个亚专科的常规诊断和精准分型。
生物制药研究:在药物研发中用于生物标志物的发现与验证,以及临床前试验的病理学评估。
基础科学研究:为细胞生物学、神经科学、发育生物学等领域提供高精度的形态学观察工具。
未来,徕卡将继续深耕于人工智能的深度集成、多组学数据的空间关联分析(如将基因组学、蛋白组学信息与形态学定位结合)以及云计算平台的拓展,进一步推动病理学从一门主观的艺术转变为客观、定量、可预测的数据科学。

徕卡病理技术代表了当今病理学实践的最高标准之一。它通过将精密工程、自动化、数字化和智能化创新深度融合,不仅夯实了病理诊断的准确基石,更正在重新定义病理学的边界。在精准医疗的时代,徕卡持续为全球的病理医生和研究人员提供着强大而可靠的技术引擎,共同描绘人类健康的更清晰图景。

电话 :

地址 :

电话 :

地址 :

电话 :

地址 :